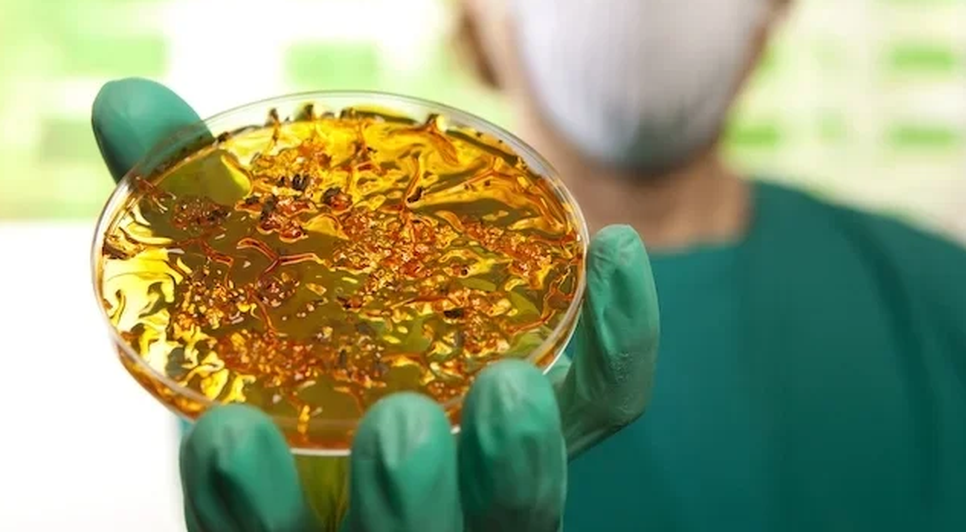

Brasil confirma primeiro caso local de cólera após 18 anos sem registros
O Brasil registrou, pela primeira vez em 18 anos, um caso autóctone de cólera, onde o paciente contraiu a doença no próprio país e não em viagem para regiões afetadas. O caso foi detectado em Salvador, na Bahia.
Nota técnica assinada pela Secretaria de Vigilância em Saúde e Ambiente informou que a bactéria causadora da doença (Vibrio cholerae) foi identificada em um homem de 60 anos, que não tinha viajado recentemente a países com ocorrência de cólera, nem tido contato com algum outro caso confirmado.
O homem apresentou sintomas de desconforto abdominal e diarreia em março, mas já está curado. A cólera é uma doença infecciosa intestinal aguda, transmitida por contaminação fecal-oral direta, ingestão de água ou alimentos contaminados e de pessoa para pessoa.
Exames realizados nas pessoas que tiveram contato com o homem contaminado e nos profissionais de saúde que o atenderam deram negativo, eliminando o risco de transmissão. A bactéria da cólera está ativa na natureza e a propagação pode ser evitada com medidas de higiene pessoal adequadas e com saneamento básico.
Receba notícias em seu WhatsApp
Participe da nossa comunidade